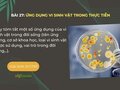
Hãy tóm tắt một số ứng dụng của vi sinh vật trong đời sống

Hãy tóm tắt một số ứng dụng của vi sinh vật trong đời sống
Hãy tóm tắt một số ứng dụng của vi sinh vật trong đời sống (tên ứng dụng, cơ sở khoa học, loại vi sinh vật được sử dụng, vai trò trong đời sống,..).
Hãy tóm tắt một số ứng dụng của vi sinh vật trong đời sống (tên ứng dụng, cơ sở khoa học, loại vi sinh vật được sử dụng, vai trò trong đời sống,..).

Trình bày cơ sở khoa học của việc ứng dụng vi sinh vật trong thực tiễn. Câu hỏi 2 trang 130 sách giáo khoa Sinh học 10 Chân trời sáng tạo

Hãy nêu các đặc điểm có lợi và gây hại của vi sinh vật đối với con người. Câu hỏi 1 trang 130 sách giáo khoa Sinh học 10 Chân trời sáng tạo

Hãy phân biệt phân bón vi sinh vật và phân bón hữu cơ vi sinh vật. Câu hỏi 3 trang 129 sách giáo khoa Sinh học 10 Chân trời sáng tạo

Hãy nêu tên một số sản phẩm có ứng dụng công nghệ và sinh vật được sản xuất ở Việt Nam. Câu hỏi 2 trang 129 sách giáo khoa Sinh học 10 CTST

Hãy tìm hiểu và lập bảng thống kê một số chủng vi sinh vật được con người ứng dụng trong đời sống hằng ngày. Câu hỏi 1 trang 129 sách giáo khoa Sinh học 10 CTST

Thực hiện dự án tìm hiểu về các sản phẩm công nghệ vi sinh vật và làm tập san các bài viết, tranh ảnh về công nghệ vi sinh vật. Câu hỏi vận dụng trang 127 sgk Sinh học 10 CTST

Hãy đề xuất một ý tưởng ứng dụng công nghệ vi sinh vật trong tương lai có thể đem lại hiệu quả cao và thúc đẩy sự phát triển kinh tế – xã hội.

Hãy nêu một số triển vọng của công nghệ vi sinh vật trong tương lai. Trả lời câu hỏi 11 trang 127 sách giáo khoa Sinh học 10 Chân trời sáng tạo

Hãy lựa chọn một ngành nghề liên quan đến công nghệ vi sinh vật mà em quan tâm và cho biết em cần chuẩn bị kiến thức, kĩ năng gì để làm tốt công việc của ngành nghề đó.